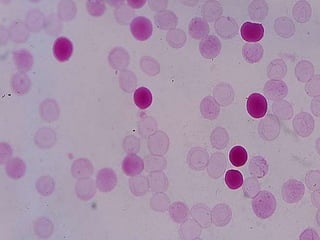

Este documento describe la eritroblastosis fetal o enfermedad hemolítica del recién nacido, la cual ocurre cuando una madre con tipo de sangre Rh negativo produce anticuerpos contra los glóbulos rojos de su feto con tipo de sangre Rh positivo. Explica los tipos de incompatibilidad sanguínea entre madre y feto, los síntomas en el feto y recién nacido, y la importancia de la inmunoglobulina RhoGAM para prevenir esta afección. También presenta el caso de una paciente cuya gemelos nacieron gravemente